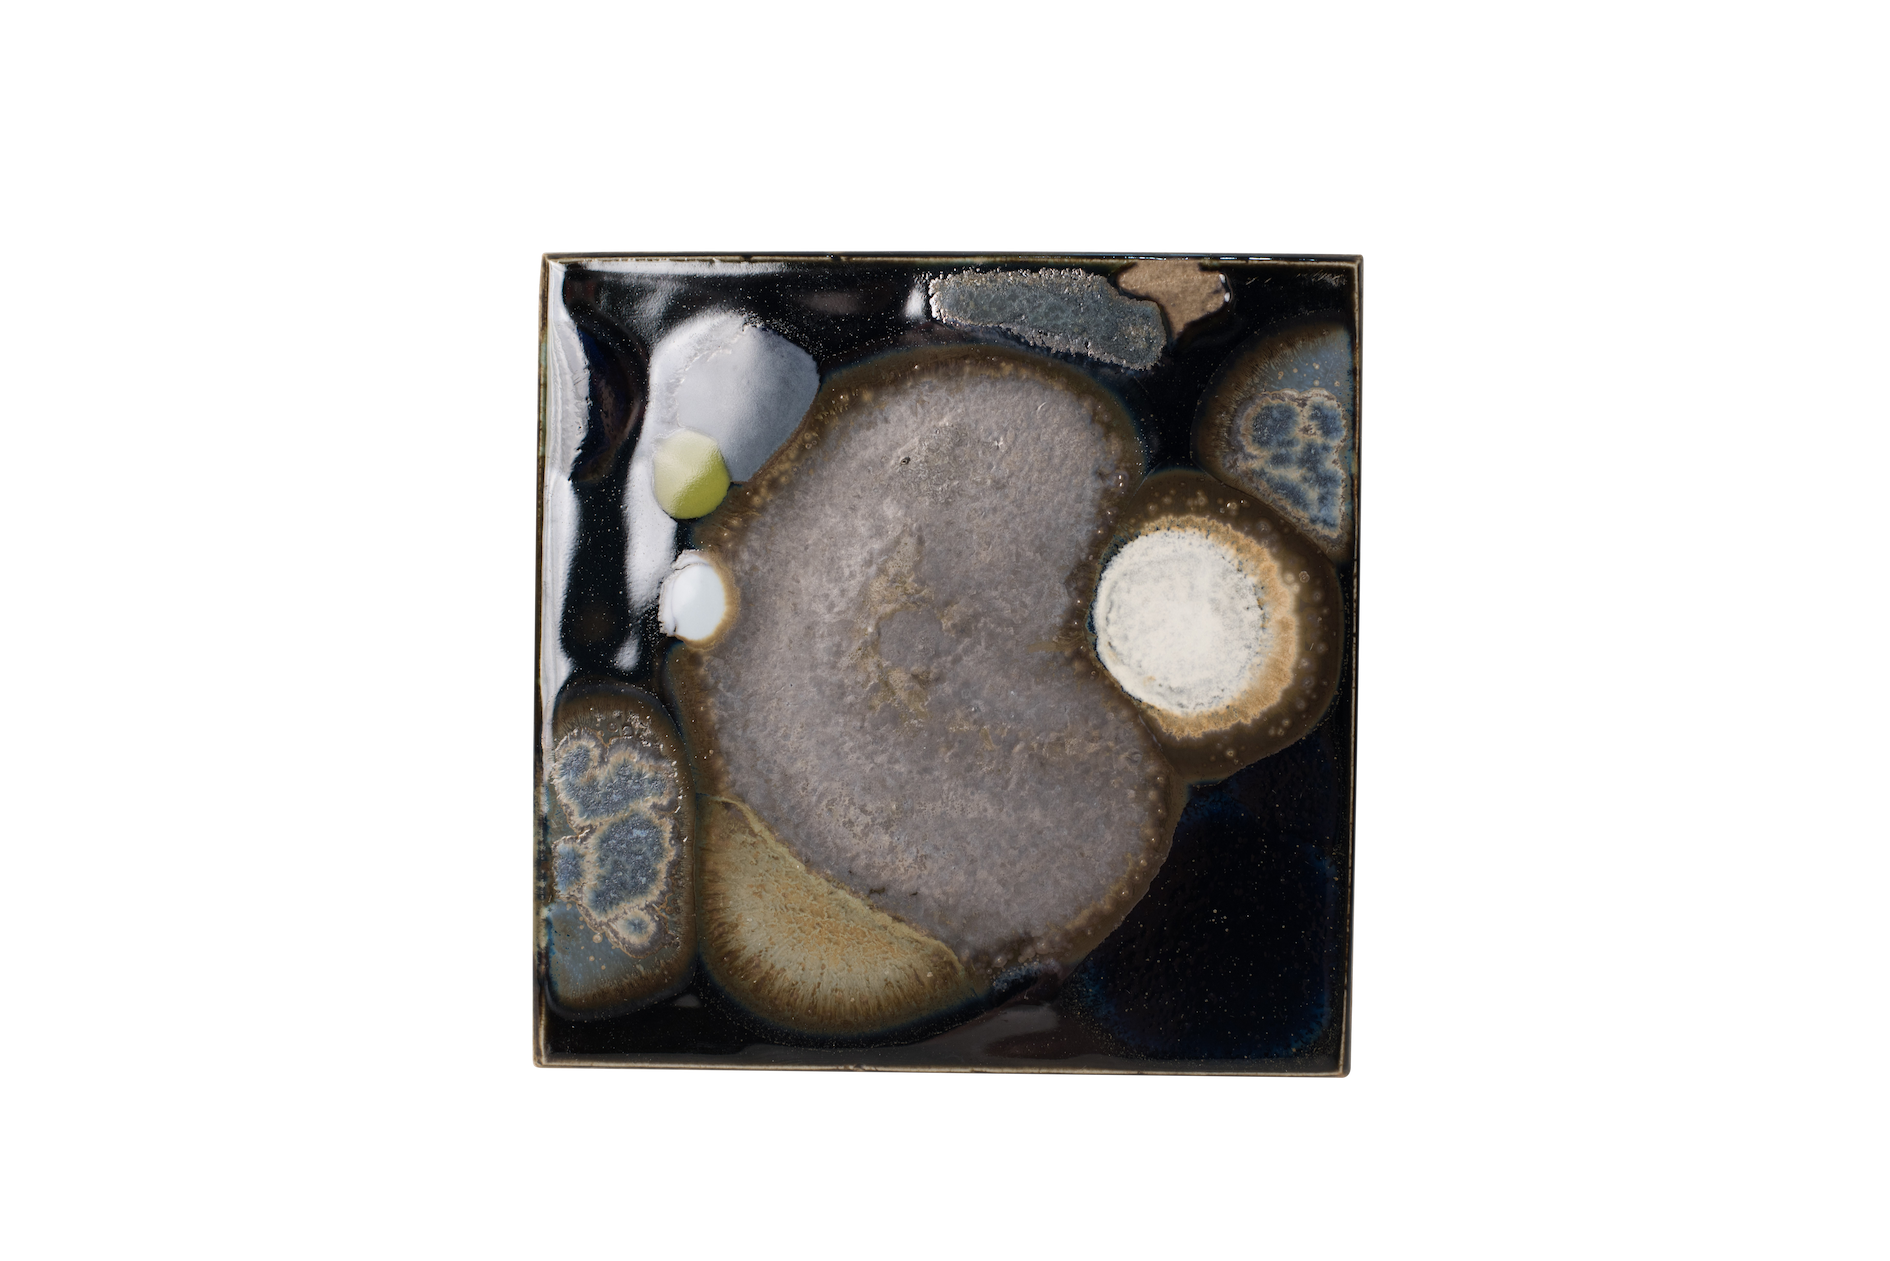
HYY_5233-3.png

Heritage is ubiquitous. In an era dominated by instant digital communication and rapid cultural shifts, many forms of heritage are quietly fading. This project proposes conserving heritage as a mentality—a way of seeing and knowing. Through ceramic glaze painting, I dematerialize heritage using visual ambiguity, creating space for personal interpretation. This project encourages viewers to turn inward, reflect on their own fading legacies, and understand heritage as a mindset—one that allows us to carry forward our culture, identity, and the things we value, even as forms change.



Glaze Painted ceramic Plates - How can I conserve human legacies through the physical design of intangible heritage?

Other Ceramic Works
A collection of ceramic works exploring wheel-thrown, hand-built, hand-painted pieces, and glaze experiments.



















